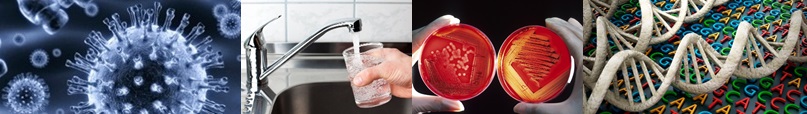

DELAWARE PUBLIC HEALTH LABORATORY
FOR INFORMATION REGARDING COVID-19, VISIT https://myhealthycommunity.dhss.delaware.gov/locations/state for state tracking and CDC.GOV for National tracking.
FOR QUESTIONS REGARDING SENDING SPECIMENS TO THE LABORATORY CONTACT THE STATE EPIDEMIOLOGY OFFICE AT (302) 744-4990.
QUICK LINKS FOR TESTS AND SERVICES
- Laboratory Information
- Infectious Disease Testing
- Drinking Water and Milk Testing
- Collection Procedures and Forms
- Preparedness and Chain of Custody forms
- Packing and Shipping Information
- Courier Routes
- State of Delaware Disease Regulations
- Outreach
- In the News
- Association of Public Health Laboratories (APHL)
- Centers for Disease Control and Prevention (CDC)
- United States Environmental Protection Agency (EPA)
This page was last updated 12/2023
Please note: Some of the files available on this page are in Adobe PDF format which requires Adobe Acrobat Reader. A free copy of Adobe Acrobat Reader can be downloaded directly from Adobe . If you are using an assistive technology unable to read Adobe PDF, please either view the corresponding text only version (if available) or visit Adobe’s Accessibility Tools page.



